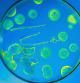
Horizontal

Tres de cada 10 europeos han tomado antibióticos en el último año, de los cuales el 20% lo hicieron para tratar un resfriado, a pesar de que un 43% de la población sabe que son infectivos contra los virus y el 66% es consciente que no funcionan para curar un catarro. Además, el 7% los tomaron sin pasar antes por la consulta de un médico.
Son algunos datos del último eurobarómetro sobre resistencias antimicrobianas, presentado durante el Día europeo para el uso prudente de los antibióticos, que se celebra el 15 de noviembre y que se enmarca en la semana mundial de concienciación sobre el uso de los antibióticos, impulsada por la Organización Mundial de la Salud (OMS).
De entre los resultados que aporta, destaca y sorprende que el 70% de los encuestados asegura que, a pesar de disponer de información acerca del correcto uso de los antibióticos, no han cambiado su forma de usarlos. Y eso que la resistencia a los antimicrobianos, esto es la capacidad que tienen las bacterias de adaptarse y hacerse resistentes a los medicamentos que usamos para combatirlas, es, seguramente, una de las mayores amenazas de salud pública global
El único arma para combatir bacterias
Descubiertos hace un siglo, los antibióticos son las únicas armas de que disponemos para luchar contra este tipo de microorganismos. Sin ellos, no hay medicina moderna. Y sin embargo, el abuso y mal uso de estos tratamientos, no solo en salud humana, sino también y sobre todo en ganadería e incluso en agricultura, ha hecho que las resistencias antimicrobianas hayan aumentado hasta el punto de que corremos el peligro de quedarnos sin ellos. Por poner un dato: solo entre 2007 y 2015, el número de muertes provocadas por Klebsiella penumoniae, una bacteria resistente a los antibióticos de último recurso, se ha multiplicado por 6.
Las cifras no son nada halagüeñas: en Europa mueren alrededor de 33.000 personas cada año como consecuencia directa de una infección provocada por una bacteria resistente a antibióticos, una cifra comparable, en palabras de Andrea Ammon, directora del Centro Europeo para el Control de Enfermedades (ECDC), “al número total de pasajeros de más de 100 aviones de tamaño medio” y que nos acerca a la era pre-antibiótico, cuando la gente moría a causa de una simple infección bucal. Y de hecho, de no lograr frenar la resistencias antimicronianas, para 2050 habrán muerto 10 millones de personas por infecciones para las que no tendremos tratamiento.
La resistencias antimicrobianas nos acercan a la era pre-antibiótico, cuando la gente moría a causa de una simple infección bucal.”
“Las resistencias antimicrobianas suponen un billón de euros anuales de gasto en salud a la Unión Europea”, ha destacado Ammon, que ha añadido que “la carga de las infecciones provocadas por bacterias resistentes a antibióticos en Europa es comparable a la de la gripe, la tuberculosis y el HIV/sida juntas”.
4,5 millones de infecciones hospitalarias
En el Día europeo para el uso prudente de los antibióticos, el ECDC también ha presentado los resultados de dos encuestas sobre las infecciones asociadas a los centros de salud, como hospitales, y sobre el uso de antimicrobianos, mayoritariamente antibióticos, en sanidad en la UE.
Y aunque las prácticas varían entre países, concluyen que se producen cada año unos 4,5 millones de infecciones asociadas a hospitales, esto es infecciones que se contraen en los centros hospitalarios, sobre todo de vías respiratorias y tracto urinario, “como si todos los habitantes de Austria adquirieran una infección hospitalaria”, de las que el 39% están ocasionadas por bacterias resistentes a los antibióticos de último recurso, como la colistina.
Ese porcentaje supone un incremento desde 2007. De hecho, se calcula que el 75% de la carga de bacterias resistentes a antibióticos se debe precisamente a las infecciones asociadas a los centros de salud, que se podían minimizar aplicando medidas simples de prevención, algunas tan sencillas como un aumento de la higiene o lavarse con frecuencia las manos, y también con la mejora del diagnóstico.

Una enfermera de la Unidad de cuidados intensivos de neonatos de un hospital de Etiopía atiende a un bebé niño de 3 días todavía sin nombre y con infección respiratoria. Los primeros 28 días son claves para la supervivencia de los neonatos.
Según estas encuestas del ECDC, en España más del 45% de los pacientes hospitalizados reciben antibióticos, en comparación con Francia o países nórdicos, en los que menos del 15% son tratados con estos medicamentos. En muchos casos, son innecesarios.
“El aumento de europeos que están muriendo o quedan incapacitados debido a infecciones que son resistentes a los antimicrobianos de que disponemos es de gran preocupación”, ha afirmado Vytenis Andriukaitis, comisario europeo para la seguridad de la salud y los alimentos durante el evento del Día europeo del antibiótico, celebrado hoy en Bruselas.
En España más del 45% de los pacientes hospitalizados reciben antibióticos, en comparación con Francia o países nórdicos, en los que menos del 15% son tratados con estos medicamentos.”
“Podemos evitar muchas de esas muertes deteniendo el uso innecesario de antimicrobianos en salud y en agricultura, y a través de mejores métodos de diagnóstico y prevención de infecciones en centros de salud”, ha añadido.
En resumen, los expertos en salud pública y epidemiología han reclamado que se haga un uso prudente de los antibióticos y han recordado que se debe tomar la dosis completa prescrita por el médico. Han recordado que se requieren medidas de prevención de infecciones, como las vacunas, tanto ya existentes como nuevas, aplicadas a toda la población y no solo a los niños, también para el ganado. Y por último han insistido en la necesidad de desarrollar nuevos antibióticos con otros mecanismos de acción que puedan resultar eficaces para combatir a las bacterias y no generen resistencias.
“Las predicciones dicen que a menos que empecemos a trabajar juntos todos, desde ganaderos a industria, farmacéuticas, políticos, médicos, sociedad, para hacer frente a esta enorme amenaza, seguramente la amenaza de salud pública más importante del siglo XXI, vamos directos hacia un desastre total, financiero y de salud global“, ha advertido Andriukaitis.

Antibióticos